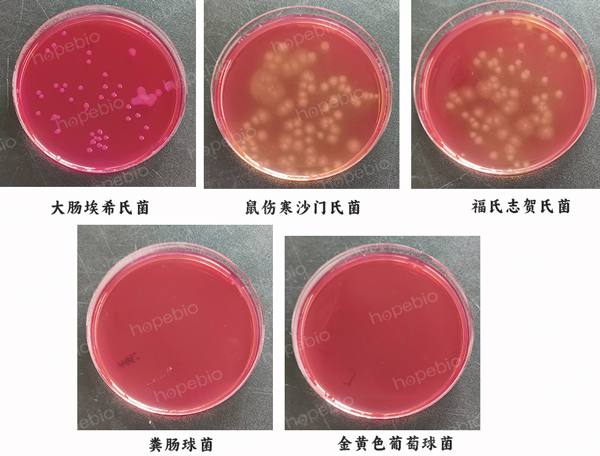

海博微信公众号
海博天猫旗舰店




一、产品用途:
用于肠道致病菌的分离培养。
二、成分(g/L):
|
蛋白胨 |
20.0 |
|
乳糖 |
10.0 |
|
三号胆盐 |
1.5 |
|
氯化钠 |
5.0 |
|
中性红 |
0.03 |
|
结晶紫 |
0.001 |
|
琼脂 |
15.0 |
|
pH值(25℃) |
7.1±0.2 |
三、检验原理:
利用胆盐来抑制革兰氏阳性细菌的生长;利用乳糖发酵,中性红的颜色可把分解乳糖和不分解乳糖的细菌区分开。志贺氏菌呈无色菌落,半透明,光滑,湿润,圆形,边缘整齐或不齐。
四、检验方法:
称取本品 51.5g,加热溶解于1000ml蒸馏水中,分装,121℃高压灭菌15分钟,备用。
五、质控结果:
按标签用法制备培养基,接种以下质控菌株,放置36±1℃需氧培养18-24h。
注:回收率计算时,用TSA琼脂做对照培养基。
|
质控菌株 |
菌株编号 |
接种量(CFU) |
回收率 |
生长情况 |
其他特征 |
|
大肠埃希氏菌 |
ATCC 8739 |
10-100 |
≥70% |
+++ |
桃红色菌落,周围有胆盐沉淀环 |
|
鼠伤寒沙门氏菌 |
ATCC 14028 |
10-100 |
≥70% |
+++ |
无色半透明菌落 |
|
金黄色葡萄球菌 |
ATCC 25923 |
100-1000 |
/ |
-/+ |
抑制或部分抑制 |
|
福氏志贺氏菌 |
ATCC 12022 |
10-100 |
≥70% |
+++ |
无色半透明菌落 |
|
粪肠球菌 |
ATCC 29212 |
100-1000 |
/ |
- |
抑制 |
细菌在麦康凯琼脂3号上的生长特征:
相关产品:
注:本文属海博生物原创,未经允许不得转载。
下一篇:没有了!
